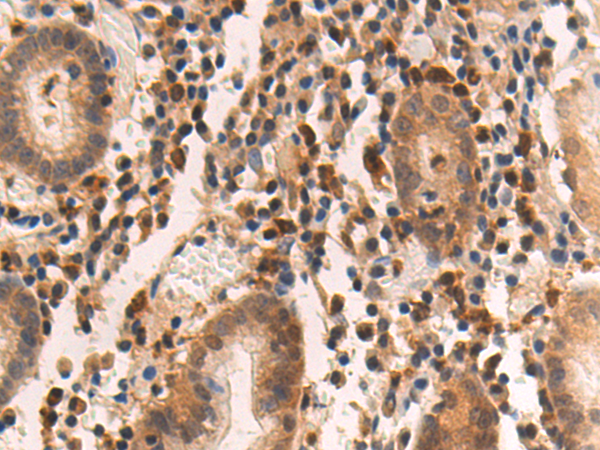

-
分类: 科研抗体货号: P03668别名: DAI; DLM1; DLM-1; C20orf183应用: WB反应种属: Human
-
分类: 科研抗体货号: P03670别名:应用: WB,IHC反应种属: Human, Mouse
-
分类: 科研抗体货号: P03699别名:应用: IHC反应种属: Human, Mouse
-
分类: 科研抗体货号: P03666别名: HLD9; RARS; ArgRS; DALRD1应用: WB,IHC反应种属: Human, Mouse, Rat
-
分类: 科研抗体货号: P03698别名: HTX; HTX1; ZNF203; VACTERLX应用: WB,IHC反应种属: Human, Mouse
-
分类: 科研抗体货号: P03665别名: AIM; EA1; MLR-3; CLEC2C; GP32/28; BL-AC/P26应用: WB反应种属: Human
-
分类: 科研抗体货号: P03697别名: HPE5应用: IHC反应种属: Human, Mouse
-
分类: 科研抗体货号: P03664别名: HSP70T; hum70t; HSP70-1L; HSP70-HOM应用: WB,IHC反应种属: Human, Mouse, Rat
-
分类: 科研抗体货号: P03696别名: TIX1应用: IHC反应种属: Human, Mouse
-
分类: 科研抗体货号: P03663别名: ASC; TMS; TMS1; CARD5; TMS-1应用: WB,IHC反应种属: Human, Mouse

鄂公网安备42018502007531号
鄂公网安备42018502007531号

